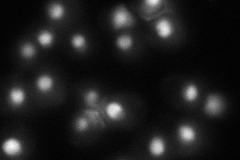

View description
Subunit of the heterodimeric FACT complex (Spt16p-Pob3p), which facilitates RNA Pol II transcription elongation through nucleosomes by destabilizing and then reassembling nucleosome structure; interacts with DNA polymerase alpha (Pol1p)
Localization:
Intensity:
Fold change:
Significance:
-
C’ GFP library in SD

nucleus71.92 -
N' NOP1pr-GFP in SD

nucleus153.288 -
N' TEF2pr-mCherry in SD

nucleus154.138 -
N' NATIVEpr-GFP in SD
nucleus55.9506 -
N' TEF2pr-VC and Cyto-VN in SD

#N/A0 -
C’ GFP library in SD+DTT

nucleus89.651.24No -
C’ GFP library in SD+H2O2

nucleus100.921.4Yes -
C’ GFP library in Starvation Media

nucleus81.851.13No -
C’ GFP library on the background of Pup2-DaMP

nucleus -
C’ GFP library on the background of CCT mutant

nucleus87.08331.21075No
